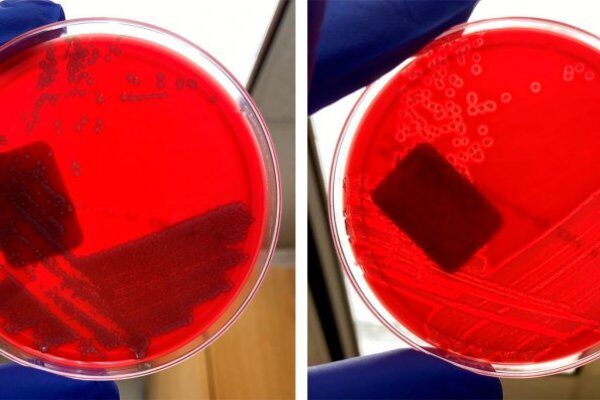
实验室诊断：大肠杆菌（腹泻）

行业资讯
-
非洲猪瘟知识介绍(1)
本文来源:养猪职业经理人,不代表本站立场,如若转载,请注明出处。非洲猪瘟JoséManuelSánchez‐Vizcaíno,AlbertoLaddomada,andMarisaL背景全球非洲猪瘟历史回顾第一次报道非洲猪瘟是在1921年的肯尼亚,当时该病(AS…
-
冬季猪场如何降低舍内湿度
本文来源:养猪职业经理人,不代表本站立场,如若转载,请注明出处。资料来源:法国欧密斯各种类型猪只最佳温度区域130公斤体重猪只所需足够的空间,完全水泥地面1.4平方每头,部分漏缝混凝土地板1.25平方每头,全…
-
2021年第47周生猪及猪肉价格环比上涨
据农业农村部监测,2021年11月22日—11月28日,全国规模以上生猪定点屠宰企业生猪平均收购价格为19.07元/公斤,环比上涨2.1%,同比下降38.3%。白条肉平均出厂价格为25.04元/公斤,环比上涨2.0%,同比下降36.4%。…
-
金新农:坚持饲料、养猪核心业务,谋求向屠宰行业拓展
2021深圳辖区上市公司投资者网上集体接待日11月30日在全景·路演天下举办,金新农财务总监、证券财务相关人员钱子龙在本次活动上回答投资者提问时表示,从他的角度看,未来3年公司最大的挑战是构建和强化生猪养殖的…
-
新一轮猪价降价潮将至!唐人神:已募近40亿元资金过冬
11月30日,唐人神接受13家机构调研,表示自去年起,先后公开发行了可转债、非公开发行股票,合计募集资金近 28 亿元,并于今年上半年联合社会资本组建了 10亿元产业基金,应对去年高猪价带来生猪产能大幅增加的压力…
-
2025年,江西家禽出栏将达6.3亿羽!八大措施推进家禽产业发展
到2025年,家禽综合生产能力稳步提升,全省禽肉产量达到95.5万吨,禽蛋产量达到75万吨,家禽出栏量达到6.3亿羽;规模化养殖水平进一步提高,家禽规模养殖比重达到75%以上;屠宰加工水平显著提升,屠宰加工能力达到3亿羽;家禽育种取得明显成效,力争培育2-3个家禽新品种、新品系;家禽产品质量安全水平提升,禽肉、禽蛋抽检合格率均保持在98%以上。
-
农业农村部《生猪产能调控实施方案(暂行)》2021年印发
各省、自治区、直辖市农业农村(农牧)、畜牧兽医厅(局、委),新疆生产建设兵团农业农村局: 为贯彻落实《农业农村部、国家发展改革委、财政部、生态环境部、商务部、银保监会关于促进生猪产业持续健康发展的意见…
-
《非洲猪瘟等重大动物疫病分区防控工作方案(试行)》2021版
为贯彻落实《中华人民共和国动物防疫法》和《国务院办公厅关于促进畜牧业高质量发展的意见》(国办发〔2020〕31号)有关要求,进一步健全完善动物疫病防控体系,我部在系统总结2019年以来中南区开展非洲猪瘟等重大…
-
振兴种业 ,专家“益”起行动 —— LPE畜禽公益云讲堂每周一期,火热更新中
种业振兴已成国之大计,相关政府机构、行业协会、企业、科研单位等竭尽所能,为国家种业发展贡献力量。为服务畜禽产业企业及从业者,共同提升从业水平和专业能力,助力种业振兴,2022世界种业论坛暨世界畜禽产业博…
-
号角吹响,集结长沙! 【第八届农牧兄弟联盟男子篮球赛】12月6-9日,精彩即将开启
号角吹响,集结长沙! 【第八届农牧兄弟联盟男子篮球赛】12月6-9日,精彩即将开启
-
实验室诊断:大肠杆菌(腹泻)
我可以使用哪些实验室诊断方法来诊断大肠杆菌?我应该根据情况选择哪一种?我如何解读结果?
-
正大康地梅州1800头原种猪场投产!2025年计划出栏种猪3万头
正大康地梅州生猪产业链项目,预估总投资规模约15亿元人民币,用地规模约5500亩,年产约30亿元人民币,其中,养殖相关项目由1个1800头原种猪场、1个1200头祖代种猪场、1个600头种公猪站、4个4800头父母代种猪场以及8个万头肉猪场构成,外加配套饲料厂、有机肥料厂、生猪屠宰场、种植基地等。
-
限制精料对妊娠母猪牧场觅食行为及植被破坏的影响
可以降低牧场上妊娠母猪浓缩料饲喂水平,而不会对牧场植被产生不利影响。
-
减少断奶应激:仔猪断奶前的社会化是一个需要考虑的策略吗?
从长远来看,哺乳期间混合饲养对仔猪有益吗?了解社会化如何影响猪的行为和生理。
-
尾巴低垂?快点行动!
一种新的,尚未测试的方法可以帮助减轻生长肥成猪的咬尾。
-
一个增加初乳产量的简单方法
在分娩结束后的16小时内给予高剂量的催产素可延长初乳期,这可以改善哺乳早期的乳汁质量。
-
同批次内分娩时长差异是否会影响屠宰体重?
在最好的情况下,同批次分娩通常会持续三天,而最坏的情况可能会持续一周以上,从而产生不同的哺乳期时长……
-
妊娠期饲喂时间有影响吗?
饲喂时间会影响繁殖性能吗?
-
不同生产阶段的猪炎症和坏死综合征
在哺乳仔猪、断奶仔猪和育肥猪中,猪炎症和坏死综合征受饲养和母猪质量的影响。
-
猪栏设计对未断尾育成猪咬尾的影响
尽管有更多尾巴导向行为的趋势,但某些猪栏改造可导致尾部受损的猪的数量的减少,且整体福利更好。
.png)